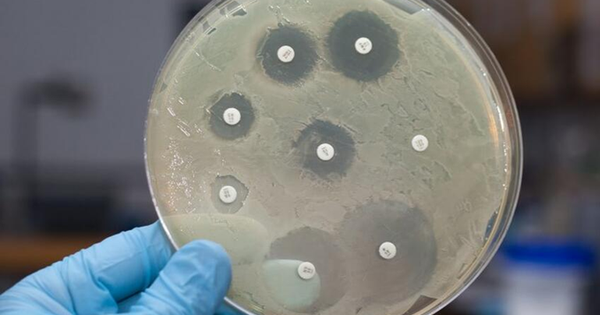

Xuân Mai, sinh năm 1995, từng được mệnh danh là “thần đồng âm nhạc” của showbiz Việt vào những năm 2000. Cô bước chân vào con đường ca hát từ rất nhỏ nhờ lớn lên trong một gia đình có truyền thống nghệ thuật: bố là ca-nhạc sĩ Tuấn Cảnh, mẹ là nghệ sĩ guitar Thu Thu. Sự nghiệp của Xuân Mai lúc bấy giờ được chính nhạc sĩ Tuấn Cảnh dìu dắt, định hướng cô trở thành một hiện tượng âm nhạc nhí nổi bật.
Khi mới 2 tuổi, Xuân Mai đã chinh phục thị trường nhạc thiếu nhi Việt Nam với những ca khúc đình đám như Con cò bé bé, Cháu yêu bà… Đến 5 tuổi, cô tổ chức liveshow riêng, biểu diễn trước hàng nghìn khán giả và trở thành một trong những cái tên được yêu mến nhất, thậm chí nổi tiếng hơn nhiều nghệ sĩ trưởng thành. Mỗi lần xuất hiện, cô bé luôn được khán giả vây quanh, có người còn chạy xe theo chỉ để được nhìn tận mắt thần tượng.

Thần đồng âm nhạc Xuân Mai
Tuy nhiên, ở đỉnh cao sự nghiệp, Xuân Mai bất ngờ theo gia đình sang Mỹ định cư từ năm 9 tuổi, khiến cô không còn nhiều điều kiện để hoạt động nghệ thuật. Mới đây, nhạc sĩ Tuấn Cảnh - bố của Xuân Mai chia sẻ lý do đưa con sang Mỹ ngay thời điểm đỉnh cao: "Lúc đó Xuân Mai lớn rồi, tôi phải cho nó trở lại Mỹ để học. Có một điều ít ai biết là bé Xuân Mai sinh ra ở Mỹ, mang quốc tịch Mỹ. Khi đưa bé về Việt Nam, vợ chồng tôi cũng cho con học trường quốc tế. Nhưng khi lớn hơn, chúng tôi phải cho con trở lại Mỹ để đảm bảo việc học, không thể cứ đi hát mãi mà quên đi việc học."

Chỉ mới 2 tuổi, Xuân Mai được cả nước biết mặt, yêu quý giọng hát
Tới năm 2009, Xuân Mai trở về Việt Nam với ý định phát triển sự nghiệp ca hát. Tuy nhiên, sự nổi tiếng quá sớm lại trở thành rào cản. Khán giả vẫn nhớ đến cô với hình ảnh “bé Xuân Mai” và khó chấp nhận sự thay đổi về ngoại hình và giọng hát của cô. Sau một thời gian ngắn, Xuân Mai quyết định trở lại Mỹ.

Xuân Mai và bố
Một thời gian sau, Xuân Mai tạm dừng việc học và kết hôn ở tuổi 21 với một Việt kiều Mỹ, khi con trai đầu lòng gần 1 tuổi. Trong vài năm tiếp theo, Xuân Mai lần lượt sinh thêm hai con, một trai, một gái với mong muốn các con gần tuổi để tiện chăm sóc và đưa đón đi học. Cuộc sống ở Mỹ cũng không dễ dàng: khi chồng đi làm xa, Xuân Mai trở thành trụ cột gia đình, làm nhiều công việc khác nhau để mưu sinh, từ phụ việc quán phở đến bán điện thoại.
Từ năm 2022, Xuân Mai không còn cập nhật quá nhiều thông tin trên mạng xã hội. Thỉnh thoảng, Xuân Mai chia sẻ những khoảnh khắc đời thường của gia đình. Khi được khán giả hỏi về việc quay lại ca hát, cô cho biết hiện vẫn chưa có kế hoạch. Theo tiết lộ của nghệ sĩ Tuấn Cảnh, hiện Xuân Mai đang làm việc tại một ngân hàng ở bang Ohio, Mỹ, vừa lo công việc vừa chăm sóc 3 con nhỏ, với cuộc sống khá vất vả nhưng ổn định.

Xuân Mai hiện tại đã trưởng thành, xây dựng tổ ấm 3 con và có cuộc sống bình thường ở Mỹ
Nhiều khán giả bày tỏ sự tiếc nuối trước hình ảnh cô bé Xuân Mai ngày nào, “thần đồng âm nhạc” với giọng hát trong trẻo, hồn nhiên khi giờ đây cô phải đối mặt với những chênh vênh trong cuộc đời và sự nghiệp. Từ ánh đèn sân khấu rực rỡ ở Việt Nam đến những thử thách mưu sinh ở xứ người, con đường của Xuân Mai cho thấy sự khác biệt rõ rệt giữa tuổi thơ nổi tiếng và đời sống trưởng thành đầy thực tế. Dù vậy, nhiều người vẫn dành sự trân trọng cho Xuân Mai, cho những đóng góp không thể phủ nhận của một “thần đồng âm nhạc” đã từng làm rạng rỡ nền nhạc thiếu nhi Việt Nam và khắc sâu ký ức trong lòng khán giả.

Năm 2022, Xuân Mai cập nhật 1 vài clip cover lên TikTok thu hút cả triệu lượt xem